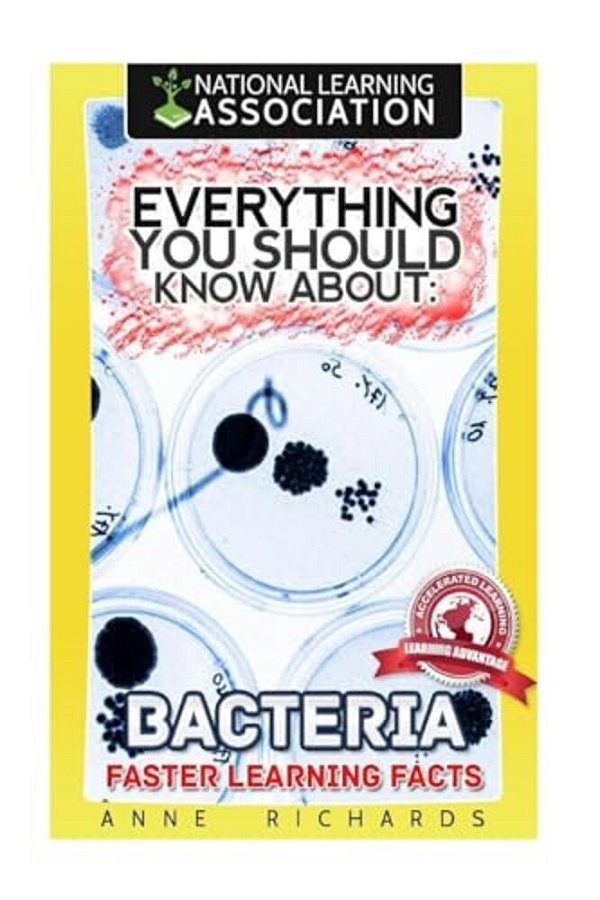
Everything You Should Know About Bacteria-..

Everything You Should Know About Bacteria-..
-
- 1x de R$ 116,12 sem juros
- 2x de R$ 58,06 sem juros
-
R$ 110,31

-
R$ 116,12

Produtos relacionados
-
 Everything You Should Know About Viruses And Bacteria-..R$ 133,88até 2x de R$ 66,94 sem jurosou R$ 127,19 via Pix
Everything You Should Know About Viruses And Bacteria-..R$ 133,88até 2x de R$ 66,94 sem jurosou R$ 127,19 via Pix -
 Everything You Should Know About Algae And Bacteria-..R$ 133,88até 2x de R$ 66,94 sem jurosou R$ 127,19 via Pix
Everything You Should Know About Algae And Bacteria-..R$ 133,88até 2x de R$ 66,94 sem jurosou R$ 127,19 via Pix
-
Categorias
Conteúdo
Sobre a loja
Myre Livraria, sua livraria online especializada em importação e revenda de livros nacionais e internacionais. Oferecemos uma vasta seleção de materiais didáticos de alta qualidade para aprender inglês, espanhol, francês, alemão e muito mais. Aproveite preços competitivos e entrega rápida em todo o Brasil
Pague com
Selos